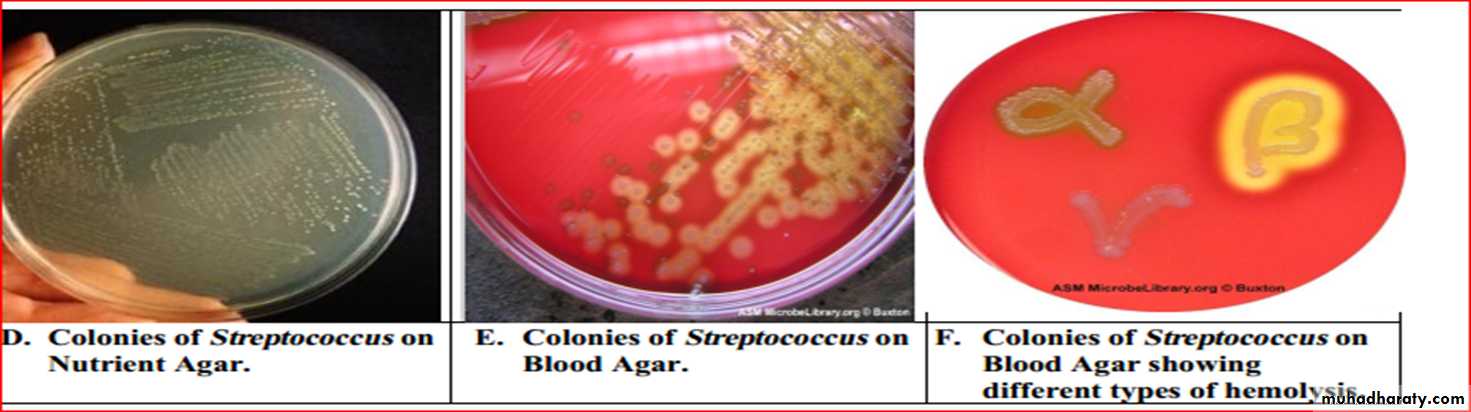
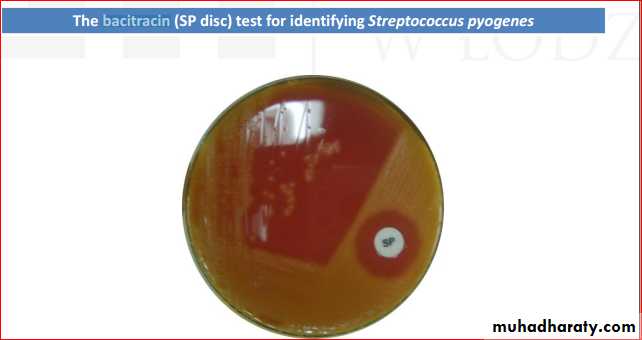
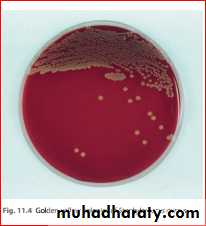

PARTMicrobes of relevance to dentistry
Streptococci
General properties1- Characteristics :- They are catalase-negative, Gram-positive spherical or oval cocci in pairs and chains; 0.7–0.9 µm in diameter. Chain formation is best seen in liquid cultures or pus.
2- Culture
These cocci grow well on blood agar, although enrichment of media with glucoseand serum may be necessary.
Typical haemolytic reactions are produced on blood agar
• α-haemolysis: narrow zone of partial haemolysis and green (viridans) discolouration around the colony, e.g.viridans streptococci
• β-haemolysis: wide, clear, translucent zone of complete
haemolysis around the colony, e.g. Streptococcus pyogenes• no haemolysis (γ-haemolysis), e.g. non-haemolytic streptococci.
Serology
The carbohydrate antigens found on the cell walls of the organisms are related to their virulence. Hence, serogrouping, termed Lancefeld grouping, is useful in the identifcation of the more virulent β-haemolytic species. Currently, 20 Lancefeld groups are recognized (A–H and K–V) but not all are equally important as human pathogens.group A includes the important human pathogenStreptococcus pyogenes
• group B contains one species, Streptococcus agalactiae, an inhabitant of the female genital tract; it causes infection in neonates
• group C mainly causes diseases in animals
• group D includes the enterococci (Enterococcus faecalis,etc.) and ranks next to group A in causing human disease.
• Streptococcus pyogenes (group A)
Habitat and transmissionThe normal habitat of this species is the human upper respiratory tract and skin;
it may survive in dust for some time.Spread is by airborne droplets and by contact.
Characteristics
It is found as a commensal in the nasopharynx of a minority of healthy adults, but more commonly (about 10%) in children.It grows well on blood agar, with a characteristic halo of β-haemolysis.
Some strains produce mucoid colonies as a result of having a hyaluronic acid capsule.
This may contribute to virulence by offering resistance to phagocytosisExotoxins and enzymes
Produces a large number of biologically active substances, such as:
• streptokinase: a protolytic enzyme that lyses fibrin
• hyaluronidase: attacks the material that binds theconnective tissue, thereby causing increasing
permeability (hence called the ‘spreading factor’)
• DNAases (streptodornases): destroy cellular DNA
• haemolysins (streptolysins, leukocidins): responsible for the characteristic erythematous rash in scarlet fever.Culture and identifcation
Culture on blood agar yields characteristic β-haemolyticcolonies (lysis of blood due to streptolysins O and S).A Gram-stained smear may show characteristic cocci in chains.
The isolate can be presumptively identifed as Streptococcus pyogenes if it is sensitive to bacitracin.
If rheumatic fever is suspected, then testing the patient’santistreptolysin O (ASO) antibody titre will demonstrateprevious exposure to Streptococcus pyogenes .
Pathogenicity
Streptococcus pyogenes causes a number of infections; the most notable are:• tonsillitis and pharyngitis• peritonsillar abscess
• otitis media (middle-ear infection)
• wound infections:- leading to . Erysipelas
• Impetigo (a skin infection) scarlet fever cellulitisImpetigo
• cellulitis
ComplicationsAfter an episode of infection, some patients develop complications, such as rheumatic fever, glomerulonephritis and erythema nodosum, which may have long-lasting effects.Note that:
• • post-streptococcal infection, manifesting as rheumatic fever, is caused by immunological cross-reaction between bacterial antigen and human heart tissue, and acute glomerulonephritis is caused by immune complexes bound to glomeruli
• in cellulitis, hyaluronidase (’spreading factor’) mediatesthe subcutaneous spread of infection
• erythrogenic toxin causes the rash of scarlet fever and psoriasis
19
Acute glomerulonephritis
Cross reaction between streptococci and kidney tissues
Treatment and prevention
Penicillin is the drug of choice; erythromycin is suitable for patients hypersensitive to penicillin. No vaccine is available.Streptococcus agalactiae (group B)
• This species is increasingly recognized as a human pathogen, especially as a cause of neonatal meningitis and sepsis.Habitat and transmission
Found in the human vagina.Babies acquire infection from the colonized mother during delivery or during nursing.Characteristics
Gram-positive cocci in chains.
Culture and identificationGram-stained smear and culture yielding β-haemolytic colonies on blood agar; colonies on blood agar are generally larger than Streptococcus pyogenes.
Lancefeld group is determined by antiserum against cell wall polysaccharide.
Pathogenicity
No toxins or virulence factors have been identifed.This species causes neonatal meningitis and septicemia
It is also associated with septic abortion and gynaecological sepsis
24Diagnostic Laboratory Tests
CAMP factor positive
Hippurase positive
25
Group A Streptococci
Oral streptococci
Oral streptococci, which live principally in the oropharynx, are a mixed group of organisms with variable characteristics.New typing techniques, particularly those based on molecular biology, have revealed the complex nature of the origin and the taxonomy of this group.Oral streptococci
Viridans Group Streptococci( No Lancefield antigen classification. Membersinclude Streptococcus salivarius, S. sanguis, S. mitis,S. intermedius, S. mutans, and others.)typically show α-haemolysis on blood agar, but this is not a constant feature as some strains are non-haemolytic and others β-haemolytic.
Oral streptococci can be divided into
four main species groups as follows:1. mutans group2. salivarius group3. anginosus group4. mitis group.
Each of these groups comprises a number of species
Streptococcus mutans
Streptococcus mutans gained notoriety in the 1960s when it was demonstrated that caries could be experimentally induced and transmitted in animals by oral inoculation with the organism.
The name ‘mutans’ results from its frequenttransition from coccal phase to coccobacillary phase.
Habitat and transmission
Streptococci make up a large proportion of the resident oral flora.It is known that roughly one-quarter of the total cultivable flora from supragingival and gingival plaque and halfof the isolates from the tongue and saliva are streptococci.
They are vertically transmitted from mother to child. Infective endocarditis caused by these organisms (loosely termed viridans streptococci) is generally a result of their entry into the blood stream during intraoral surgical procedures (e.g. tooth extraction), and sometimes even during tooth-brushing
Transmission
VerticalParent to child
Horizontal
Non-parent same species transfer
Culture and identifcation
Gram-positive cocci in chains;α-haemolytic;
Catalase negative.
Growth not inhibited by bile or optochin in contrast to pneumococci.
Pathogenicity
The mutans group of streptococci are the major agents of dental caries (but in the absence of predisposing factors, such as sucrose, they cannot cause caries). They have a characteristic ability to produce voluminous amounts of sticky, extracellular polysaccharides in the presence of dietary carbohydrates these help tenacious binding ofthe organisms to enamel and to each other.
They are also important agents of infective endocarditis, and some 60% of cases are due to this organism.
Usually, bacteria released during dental procedures settle on damaged heart valves, causing infective endocarditis.
Biofilm Formation
Treatment and prevention
In patients at risk of infective endocarditis (e.g. those with damaged or prosthetic heart valves), prophylactic antibiotic cover should always be given before dental proceduresCurrently, seven distinct species of human and animal mutans streptococci and eight serotypes (a–h) are recognized, based on the antigenic specifcity of cell wall carbohydrates. The term Streptococcus mutans is limited to human isolates belonging to three serotypes (c, e and f)
The Mutans Streptococcus
• Species
• Serotype
• Source
• S. mutans
• c,e,f
• Human
• S. sobrinus
• d,g,h
• Human
• S. cricetus
• a
• Sometimes human, mostly rats and hamsters
• S. rattus
• b
• Sometimes humans, mostly rats
• S. downei
• h
• Macaque monkey
• S. macacae
• c
• Macaque monkey
• S. ferus
• c
• Rats
Streptococcus pneumoniae (pneumococcus)
This organism causes a number of common diseases, such as pneumonia and meningitis in adults and otitis media and sinusitis in children
A normal commensal in the human upper respiratory tract; up to 4% of the population carry this bacteria in small numbers.
Transmission is via respiratory droplets.
Characteristics
Gram-positive ‘lancet-shaped’ cocci in pairs (diplococci) or short chains; cells are often capsulate; α-haemolytic on blood agar; catalase-negative; facultative anaerobe(i.e. grows under both aerobic and anaerobic conditions
Culture and identifcation
Forms α-haemolytic colonies. After incubation for 2 days,the colonies appear typically as ‘draughtsmen’ because of their central indentation (a result of spontaneous autolysis of older bacteria in the centre of the colony).The species is differentiated from other α-haemolytic streptococci by its sensitivity to optochin and solubility in bile.
Observation for the capsular swelling with type-specific antiserum (quellung reaction) confirms the identity and is the standard reference method.
The latex agglutination test for capsular antigen in spinal fluid can be diagnostic.
Pathogenicity
Although no exotoxins are known, this organism induces aninflammatory response. The substantive polysaccharidecapsule retards phagocytosis. Vaccination with antipolysaccharide vaccine helps provide type-specifc immunity.Viral respiratory infection predisposes to pneumococcal pneumonia by damaging the mucociliary lining of the upper respiratory tract (the mucociliary escalator).
Other common diseases caused by pneumococci include lobar pneumonia, acute exacerbation of chronic bronchitis, otitis media, sinusitis, conjunctivitis, meningitis and, in splenectomized patients, septicaemia
Treatment and prevention
Penicillin or erythromycin is very effective. However, resistance to penicillin is rapidly emerging as a global concernStaphylococci
Staphylococci are also Gram-positive cocci, but, unlike the chains of streptococci, they are arranged in characteristic grape-like clusters. The Staphylococcus genus contains morethan 15 different species, of which the following are ofmedical importance: Staphylococcus aureus, Staphylococcus epidermidis and Staphylococcus saprophyticus.Staphylococci cause a variety of both common and uncommon infections, such as abscesses of many organs, endocarditis, gastroenteritis (food-poisoning) and toxic shock syndrome.
They are not infrequent isolates from the oralcavity. Higher proportions of Staphylococcus aureus are found in the saliva of healthy subjects older than 70 years.
Staphylococcus aureusHabitat and transmission
The habitat is the human skin, especially the anterior nares and the perineum. Domesticated animals also carry staphylococci. Higher carriage rates are seen in hospital patients and staff.These bacteria are disseminated through air anddust and are always present in the hospital environment.
The usual transmission route is via the hands and fngertips.
Characteristics
Gram-positive cocci in clusters (cluster formation is due to their ability to divide in many planes); non-sporing, nonmotile; some strains are capsulateCulture and identifcation
Grows aerobically as yellow or gold colonies on blood agar, catalase-positive (this differentiates them fromthe catalase-negative streptococci).Other tests used to differentiate the more virulent Staphylococcus aureus from the less pathogenic Staphylococcus epidermidis include the following.Coagulase test
Staphylococcus aureus coagulates dilute human serum or rabbit plasma (i.e. it is coagulase-positive), whereas Staphylococcus epidermidis does not (coagulase-negative).This test could be done either in a test tube (the tube test), which requires overnight incubation or on a slide (the slide test), which is a rapid test.
Protein A – latex agglutination test
Protein A, synthesized by almost all strains of Staphylococcus aureus, has a special affnity to the Fc fragment of immunoglobulin G (IgG). Hence, when latex particles coated with IgG (and fbrinogen) are mixed with an emulsifed suspension of Staphylococcus aureus on a glass slide, visible agglutination of the latex particles occurs; no such reaction is seen with Staphylococcus epidermidiOther tests
These include the phosphatase test, DNAase test and mannitol fermentation test (most strains of Staphylococcus aureus form acid from mannitol, while few Staphylococcus epidermidis do so)Typing of Staphylococcus aureus
Typing is important to determine the source of an outbreak of infection. This was commonly done by the pattern of susceptibility to a set of more than 20 bacteriophages – phage-typing and serotyping.
These methods are currently supplanted by molecular typing techniques. Antibiotic susceptibility patterns are also helpful in tracing the source ofoutbreaks
Pathogenicity
A variety of enzymes and toxins are produced by Staphylococcus aureus,The two most important are coagulase and enterotoxin. Coagulase is the best correlate of pathogenicity.
superfcial infections: common agent of boils, carbuncles, pustules, abscesses, conjunctivitis and wound infections; rarely causes oral infections; may cause angular cheilitis (together with the yeast Candida)at the angles of the mouth.
Some of the diseases caused by Staphylococcusaureus are
food poisoning (vomiting and diarrhoea) caused by enterotoxins phenomenon (multiresistance) is common, particularly in strains isolated from hospitals; these cause hospital (nosocomial) infection. Penicillin resistance is due to the production of β-lactamase encoded by plasmids. The enzyme destroys the effcacy of antibiotics with a β-lactam ring (i.e.the penicillin group drugs).Antibiotics active against Staphylococcus aureus include penicillin for sensitive isolates, flucloxacillin (stable againstβ-lactamase), erythromycin, fusidic acid (useful for skininfections), cephalosporins and vancomycin.Cleanliness, hand-washing and aseptic management of lesions reduce the spread of staphylococci
Antibiotic resistance in staphylococci
This is a global problem of much concern and falls into several classes.• resistance to β-lactam drugs• resistance to methicillin (and to nafcillin and oxacillin) independent of β-lactamase. The spread of methicillinresistant Staphylococcus aureus (MRSA) worldwide is posing problems in many community and hospitalsettings
• resistance to vancomycin, one of the last-line defences against staphylococci and the emergence of vancomycin-resistant Staphylococcus aureus (VRSA).
.The mechanism of resistance here is due to alterations in the cell wall• ’tolerance’, where the organism is inhibited but not killed by the antibiotic (i.e. there is a large difference between minimum inhibitory concentration and minimum bactericidal concentration), leading to prolonged course of infections (e.g. staphylococcal infective endocarditis)
Staphylococcus epidermidisHabitat and transmission
This species is found on the skin surface and is spread by contact
Culture and identificationGrows as white colonies on blood agar, hence the earlier name Staphylococcus albus; catalase-positive; coagulase negative; biochemically characterized by commercially available kits (e.g. API Staph)
Pathogenicity
Being a normal commensal of the skin, this bacteriumcauses infection only when an opportunity arises (it is an opportunist pathogen). Common examples are catheterrelated sepsis, infection of artifcial joints and urinary tract infections.TreatmentStaphylococcus epidermidis exhibits resistance to a number of drugs (multiresistance), including penicillin and methicillin. It is sensitive to vancomycin
Staphylococcus saprophyticus
This organism causes urinary tract infections in women, an infection especially associated with intercourse. It has the ability to colonize the periurethral skin and the mucosa.The organism can be differentiated from Staphylococcus epidermidis (both grow as white colonies on blood agar) by the mannitol fermentation reaction and other biochemical tests .
Micrococci
Micrococci are catalase-positive organisms similar to staphylococci. They are coagulase-negative and usually grow as white colonies on blood agar, although some species are brightly pigmented – pink, orange or yellow.Stomatococcus mucilagenosus, formerly classifed in the genus Micrococcus, is found in abundance on the lingual surface.
This species has the ability to produce an extracellular slime, which correlates with its predilection for thelingual surface. Its role in disease, if any, is unknown